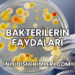
Bakterilerin Faydaları

Hamilelik süreci, anne adaylarının beslenme düzenine özen göstermesi gereken bir dönemdir. Bu dönemde Bademin Hamilelere faydaları, hem anne hem de bebeğin sağlığı için çeşitli faydalar sunar.
Badem Nedir ve Ne İşe Yarar?
Badem, Prunus dulcis ağacının yenilebilir tohumudur ve sağlıklı yağlar, protein, vitaminler ve mineraller açısından zengin bir kuruyemiştir. Düzenli badem tüketimi, kalp sağlığını destekler, enerji seviyelerini artırır ve sindirim sistemini düzenler.

Hamilelikte Badem Tüketiminin Faydaları
Hamilelik döneminde badem tüketimi, anne ve bebeğin sağlığı üzerinde olumlu etkilere sahiptir. Badem, içerdiği folik asit sayesinde bebeğin omurilik ve beyin gelişimini destekler. Ayrıca, E vitamini ve magnezyum içeriğiyle annenin kemik sağlığını korur ve enerji seviyelerini yükseltir. Lif açısından zengin olması nedeniyle kabızlık sorunlarına karşı da etkilidir.
Bademin Hamilelikte Bebek Gelişimine Etkisi
Badem, omega-3 ve omega-6 yağ asitleri ile folik asit içeriği sayesinde bebeğin beyin gelişimini destekler. İspanya’da yapılan bir araştırma, hamileliğin ilk üç ayında badem gibi sert kabuklu yemişleri tüketen annelerin çocuklarının bilişsel fonksiyonlarının daha gelişkin olduğunu göstermektedir.
Hamilelikte Badem Tüketirken Dikkat Edilmesi Gerekenler
Hamilelik döneminde badem tüketirken porsiyon kontrolüne dikkat edilmelidir. Aşırı tüketim, yüksek kalori içeriği nedeniyle kilo artışına neden olabilir. Ayrıca, badem alerjisi olan kişilerin tüketimden kaçınması önemlidir. Bademin çiğ ve tuzsuz olarak tercih edilmesi, sodyum alımını kontrol altında tutmak açısından faydalıdır.

Hamilelikte Badem Nasıl Tüketilmelidir?
Hamilelikte badem, günlük beslenme düzenine farklı şekillerde eklenebilir. Örneğin, sabah kahvaltısında yoğurt veya yulaf ezmesine eklenerek tüketilebilir. Ayrıca, ara öğünlerde sağlıklı bir atıştırmalık olarak tercih edilebilir. Günlük olarak 10-15 adet çiğ badem tüketimi, hem anne hem de bebeğin sağlığı için yeterli olacaktır.
Sıkça Sorulan Sorular
Hamilelikte badem tüketimi hakkında sıkça sorulan sorular ve yanıtları aşağıda sunulmuştur.
Hamilelikte badem yemek güvenli midir?
Evet, hamilelikte badem yemek genellikle güvenlidir ve anne ile bebeğin sağlığına çeşitli faydalar sağlar. Ancak, badem alerjisi olan kişilerin tüketmemesi önemlidir. Herhangi bir şüpheniz varsa, doktorunuza danışmanız tavsiye edilir.

Hamilelikte badem ne kadar tüketilmelidir?
Günlük olarak 10-15 adet çiğ ve tuzsuz badem tüketimi, hamilelik döneminde yeterli ve faydalı olacaktır. Aşırı tüketimden kaçınılmalı ve dengeli bir beslenme programı izlenmelidir.
Bademin hamilelikte kilo alımına etkisi var mıdır?
Badem, yüksek kalorili bir besin olduğundan aşırı tüketimi kilo alımına neden olabilir. Ancak, kontrollü porsiyonlarda tüketildiğinde sağlıklı yağlar ve protein içeriği sayesinde tokluk hissi sağlar ve gereksiz kalori alımını önleyebilir.
Hamilelikte badem tüketimi bebeğin zekasını etkiler mi?
Evet, badem içerdiği omega-3 ve omega-6 yağ asitleri ile folik asit sayesinde bebeğin beyin gelişimini destekler ve bilişsel fonksiyonlarının gelişimine katkı sağlar. Bu nedenle, hamilelikte badem tüketimi bebeğin zekası üzerinde olumlu etkilere sahip olabilir.
Hamilelikte badem sütü tüketilebilir mi?
Evet, badem sütü de hamilelikte tüketilebilir ve kalsiyum ile D vitamini açısından zengin bir alternatiftir. Ancak, badem sütü tüketirken şeker ilavesiz ve doğal olanları tercih etmek önemlidir. Herhangi bir alerji durumunda ise tüketimden kaçınılmalıdır.
Hamilelik döneminde badem tüketimi, hem anne hem de bebeğin sağlığı için çeşitli faydalar sunar. Ancak, her besinde olduğu gibi, badem tüketiminde de dengeli ve kontrollü olmak önemlidir. Herhangi bir sağlık sorunu veya alerji durumunda doktorunuza danışmanız tavsiye edilir.